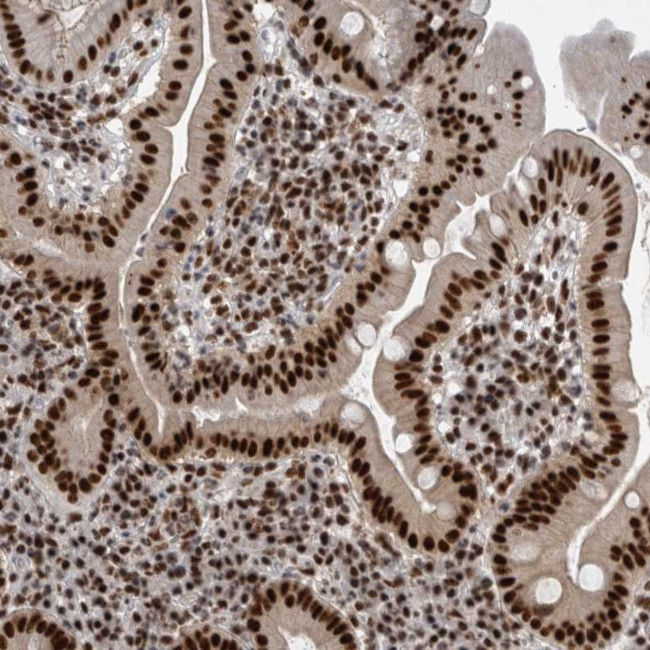
CDK11A Antibody in Immunohistochemistry (Paraffin) (IHC (P))

Search
Invitrogen
CDK11A Polyclonal Antibody
{{$productOrderCtrl.translations['antibody.pdp.commerceCard.promotion.promotions']}}
{{$productOrderCtrl.translations['antibody.pdp.commerceCard.promotion.viewpromo']}}
{{$productOrderCtrl.translations['antibody.pdp.commerceCard.promotion.promocode']}}: {{promo.promoCode}} {{promo.promoTitle}} {{promo.promoDescription}}. {{$productOrderCtrl.translations['antibody.pdp.commerceCard.promotion.learnmore']}}

Please note: We are reviewing Western blot images included in the antibody testing data in our catalog, including those provided by third parties. Unless expressly labeled or annotated as “raw-unedited”, Western blot images included in the antibody testing data in our catalog may have been edited, optimized or otherwise adjusted for presentation.
产品信息
PA5-55217
种属反应
宿主/亚型
分类
类型
抗原
偶联物
形式
浓度
规格
纯化类型
保存液
内含物
保存条件
运输条件
RRID
产品详细信息
Immunogen sequence: YRREDSMEDR GEEDDSLAIK PPQQMSWKEK VHHRKDEKRK EKCRHHSHSA EGGKHARVKE REHERRKRHR EEQDKARREW ERQKRREMAR EHSRRERDRL E
Highest antigen sequence identity to the following orthologs: Mouse - 94%, Rat - 94%.
靶标信息
The PITSLRE beta1 protein, a distantly related member of the Cdk family of protein kinases, induces apoptosis after low levels of ectopic expression. Apoptosis, or programmed cell death, is similarly induced by ectopic expression of an amino terminal deletion mutant retaining the catalytic and carboxyterminal domains of PITSLRE beta1, but not by other mutants lacking Histone H1 kinase activity or by other Cdk family members. The terminology for the ten isoforms of the PITSLRE subfamily of proteins is based on the conserved PSTAIRE box region of Cdc2 p34. Depending on which of the PITSLRE genes produce the protein, the cDNA and protein are designated alpha, beta or gamma (i.e., PITSLRE A gene, alpha; PITSLRE B gene, beta and PITSLRE C gene, gamma). Some of the isoforms such as PITSLRE alpha1 (T cells) and PITSLRE beta1 (B cells and brain), are expressed in specific cell types, while others are expressed ubiquitously.
仅用于科研。不用于诊断过程。未经明确授权不得转售。
篇参考文献 (0)
生物信息学
蛋白别名: CDK11 p110; CDK11 p46; CDK11 p58; Cell division cycle 2-like protein kinase 2; Cell division protein kinase 11A; Cyclin-dependent kinase 11A; Galactosyltransferase-associated protein kinase p58/GTA; PITSLRE serine/threonine-protein kinase CDC2L2
基因别名: CDC2L2; CDC2L3; CDK11A; PITSLREB
Entrez Gene ID: (Human) 728642